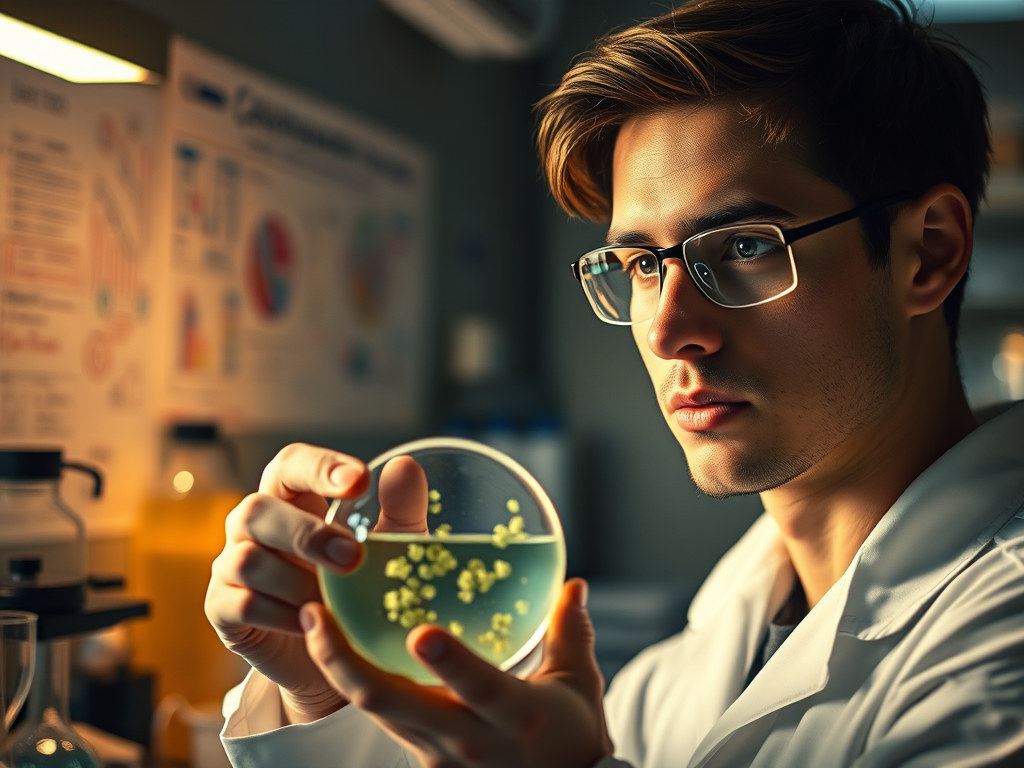

Un joven microbiólogo con 20 años llamado Albert Schatz descubre la estreptomicina, un antibiótico que ayudará a combatir la tuberculosis, pero será su jefe, Selman Waksman, quien se apropiará del descubrimiento y aunque tras la demanda del alumno y acuerdo de compartir el descubrimiento obtendrá el Premio Nobel de Medicina de 1952.
Contexto del Descubrimiento.
Investigación sobre Antibióticos: Durante la década de 1940, la tuberculosis era una enfermedad devastadora y muy difícil de tratar.
Los científicos estaban en búsqueda de compuestos que pudieran combatirla. Waksman, un microbiólogo reconocido, había estado investigando diferentes microorganismos para encontrar antibióticos.
El Aislamiento de la Estreptomicina: Mientras trabajaba como estudiante de posgrado bajo la supervisión de Waksman en la Universidad de Rutgers, Schatz descubrió la estreptomicina en un cultivo de Streptomyces griseus, un hongo del suelo.
Este antibiótico resultó ser eficaz no solo contra la tuberculosis, sino también contra otras infecciones bacterianas.
Controversia y Reconocimiento: Aunque Schatz había hecho el descubrimiento, la atribución del mérito fue un punto de conflicto.
Waksman, quien lideraba el proyecto, fue quien presentó el trabajo a la comunidad científica y solicitó la patente. La situación se volvió tensa, y Schatz finalmente demandó a Waksman y la universidad.
Como resultado, se llegó a un acuerdo que le otorgó a Schatz parte del crédito por el descubrimiento.
Premio Nobel de Medicina: En 1952, Selman Waksman recibió el Premio Nobel de Medicina por su contribución al desarrollo de la estreptomicina y otros antibióticos.
A pesar de su notable descubrimiento, Schatz no fue incluido en la premiación, lo que ha llevado a debates sobre la ética de la atribución en la ciencia.
Impacto de la Estreptomicina: La introducción de la estreptomicina en la práctica clínica revolucionó el tratamiento de la tuberculosis, salvando innumerables vidas y marcando el comienzo de una nueva era en la terapia antimicrobiana. Con el tiempo, la estreptomicina y otros antibióticos han sido fundamentales en la lucha contra diversas infecciones bacterianas.
Legado de Albert Schatz: Aunque inicialmente pasó desapercibido, el legado de Albert Schatz como descubridor de la estreptomicina ha sido reconocido con el tiempo. Su historia pone de manifiesto la importancia de la ética en la ciencia y el reconocimiento adecuado de las contribuciones de todos los investigadores involucrados en un descubrimiento.
El descubrimiento de la estreptomicina no solo representó un avance médico significativo, sino que también destacó las complejidades de la investigación científica y las dinámicas de poder en el ámbito académico.